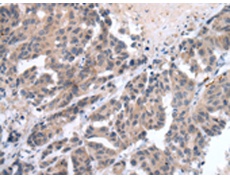
一抗

|
Background: |
The protein encoded by this gene is a member of the platelet-derived growth factor/vascular endothelial growth factor (PDGF/VEGF) family and is active in angiogenesis, lymphangiogenesis, and endothelial cell growth. This secreted protein undergoes a complex proteolytic maturation, generating multiple processed forms which bind and activate VEGFR-2 and VEGFR-3 receptors. This protein is structurally and functionally similar to vascular endothelial growth factor C. Read-through transcription has been observed between this locus and the upstream PIR (GeneID 8544) locus. [provided by RefSeq, Feb 2011] |
|
Applications: |
ELISA, IHC |
|
Name of antibody: |
VEGFD |
|
Immunogen: |
Synthetic peptide of human VEGFD |
|
Full name: |
vascular endothelial growth factor D |
|
Synonyms: |
FIGF; VEGF-D |
|
SwissProt: |
O43915 |
|
IHC positive control: |
Human breast cancer and Human gastric cancer |
|
IHC Recommend dilution: |
25-100 |

 購物車
購物車 幫助
幫助
 021-54845833/15800441009
021-54845833/15800441009